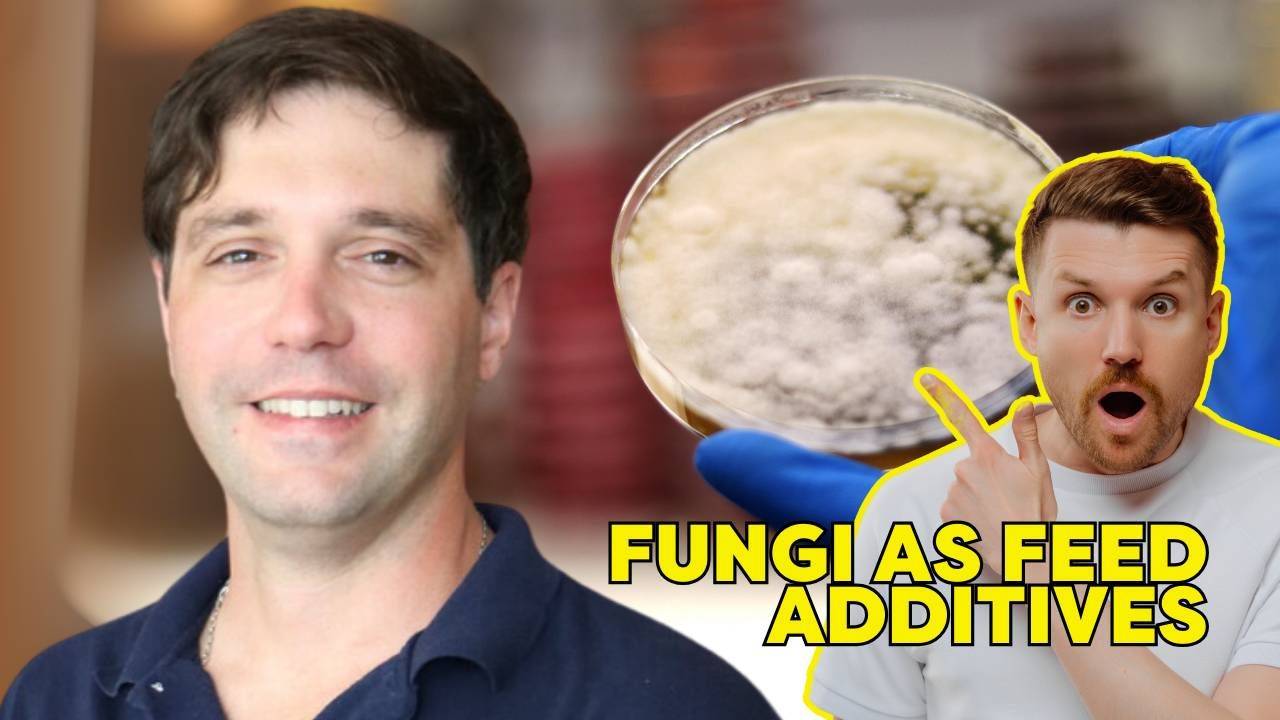

The Feed Science Podcast Show - Dr. Federico Podversich: Probiotics vs. Postbiotics | Ep. 62
Sep 03, 2024In this episode of The Feed Science Podcast Show, Dr. Federico Podversich, a graduate research assistant at the University of Florida, shares his extensive research on feed additives, with a special focus on how fungal products like Aspergillus oryzae can benefit ruminant nutrition. Dr. Podversich discusses the practical ways these additives can enhance nutrient utilization and boost animal performance. Discover how to optimize feed strategies for the livestock industry. Tune in now on all major platforms.
What will you learn:
- Probiotics vs. postbiotics
- Rumen health strategies
- Feed efficiency improvements
- Sustainability in feeding
- Nutrient utilization benefits
Meet the guest:
Dr. Federico Podversich is a Graduate Research Assistant at the University of Florida, pursuing his PhD in Animal Sciences. With a strong background in ruminant nutrition, Dr. Podversich focuses on improving feed efficiency and animal performance through innovative feed additives. His research has practical applications for enhancing sustainability in the feed industry.
Connect with our guest on Social Media: LinkedIn


